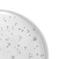

се обърнете по
време,
приложения за тестване ще направят експериментирането с различни грим продукти съвсем безпроблемно.
Едно от най-новите ни творения е серия Novage+ Restore. Продуктите от нея са създадени с цел да противодействат на хормоналното стареене, благодарение на новата ни патентована технология Bio-Boost. Клинично доказано е, че тя увеличава дебелината на епидермиса на кожата, а Орифлейм
ORIFLAME
48039 Bright Burgundy
ексфолират повърхността на кожата, а бета-хидрокси киселините, като салициловата киселина, почистват порите в дълбочина, за да осигурят мощно и цялостно ексфолиране.
BHA/AHA
върху устните
и кожата толкова често, колкото е необходимо,
като се фокусирате върху сухите участъци. Може да
използвате за подхранване и омекотяване на сухите участъци на лицето и тялото, като устни, кожички на
ноктите, ръце, вежди, лакти и стъпала.
ЗНАЕТЕ ЛИ, ЧЕ?
Нашите екстракти
са органично сертифицирани.
Това означава, че растенията
се отглеждат, берат и обработват
без употребата на химикали.
ЗВЕЗДНИ СЪСТАВКИ
Как: Bio CollagenPro
+ патентована
технология Oripeptide-3
Орипептид-3 Патент №. SE531484.
Как: Bio Sebum Control
+ патентована
технология Oripeptide-3
Как: патентовани технологии Bio LumiLock + Oripeptide-3
Bio Lumilock Патент №. SE2862600.
Как: патентовани технологии Bio-Boost + Oripeptide-3
Bio-Boost Патент №. SE542639.
ВАШАТА
маслена
мазна кожа,
но това олио-мляко е брилянтно!" #
# Спонтанен потребителски коментар
ЗНАЕТЕ ЛИ, ЧЕ?
Клетъчната обмяна се
забавя с напредването на
възрастта, поради което кожата губи блясъка си.
С формула, която стимулира
клетъчното обновяване
ПО-ПОВДИГНАТА
КОЖА В
ОКОЛООЧНАТА
ЗОНА
НОЩТА ЗА БОРБА СРЕЩУ
СТАРЕЕНЕТО НА КОЖАТА
"Кожата ми е сияйна и по-гладка,
а фините линии са
доста по-малко" #
# Спонтанен потребителски
коментар.
от императорски ирис, който интензивно
хидратира, възвръща здравината и помага за
повишаване на еластичността, докато
СВЕЖА КОЖА,
КРЕМОВЕ
Ниацинамидът помага за укрепване на кожната бариера и намалява загубата
10
ПОЛЗИ В 1!
• Хидратира
• Подпомага запазването на баланса на кожния микробиом
• Подсилва блясъка*
• Изравнява тена на кожата*
• Намалява появата на фини линии*
• Изглажда*
• Прави кожата по-плътна*
• Намалява появата на пори*
• Защитава от замърсяване
•
* Тестван от потребителите
∆ Клинично тестван.
подмладяващ
41635 Nonstop Nude
Компактна пудра THE ONE Everlasting 10 г
28.00 лв. 18.99 лв.
14.32 € 9.71 €
Най-ниската
Матиращ фон дьо тен THE ONE Everlasting Sync SPF 10 & UVA защита 30 мл
27.00 лв. 16.99 лв.
13.80 € 8.69 €
Най-ниската
Flawless Canvas
Layers Of You
14 x 1 cm. Материал:
неръждаема стомана. ABS.
•
се върху кожата, като помага да
Представяме
Гривна Giordani
колекция, която отбелязва
10 години от създаването
на емблематичния аромат Със символа на GG, отразяващ дизайна на флакона Essenza.
Чанта Layers Of You
Размер: чанта: 27 x 16 x 21 cm.
Слънчеви очила Layers Of You Размер:
С две страни
Тази есен се обгърнете
в луксозна топлина с
универсален
предлага
Шал Layers Of You
Размер: 184 x 72 cm.
Материал: полиестер. 47937 52.00 лв.
Висококонцентрирана
мандарини
елегантност Крем
по-млада
Попаднали сте в безкрайния
формулата TCI-1,
GLP-1 (Lin et al., 2024)
Източник на цинк.
Цинкът допринася за нормалния метаболизъм на въглехидратите С високо съдържание на мед. Медта допринася за нормалното
Здравият и разнообразен чревен
начини, включително на имунната система, метаболизма, апетита и емоциите (Dupont et al., 2020).
храната: Добавете 5 г (приблизително 1½ ч.л.) към храната
Като напитка:
Термо чаша Wellosophy
Чаша: 9 x 13,6 x 28 cm.
Сламка: 0,8 x 25,5 см.
Материал: Неръждаема
стомана, пластмаса AS, PP, силикон. 48543 63.00 лв. 44.99 лв. 32.21 € 23.00 €
Най-ниската цена за периода от 30 дни преди тази оферта е била 38.99 лв. 19.94 €
Шейкър Wellosophy Smartshake
Размер: 22 х 9,5 см.
Отделение за течности: 600мл. Отделение с разделител: 140мл.
Основно отделение: 200 мл.
Материали: PP, PE и
неръждаема стомана. 46664 25.99 лв. 13.29 €
Лъжица Wellosophy
Размер: 11,2 x 4,2 cm
Материал: PP. 46068 2.00 лв. 1.02 €
4 на цената на 3!
Изберете комплект, който отговаря на вашите нужди, абонирайте
се и персонализирайте компонентите. През първите 3 каталога закупувате комплекта на пълна цена.
Комплект "Здраве" Wellosophy
Гаранция за най-добра цена
Не е необходимо да заплащате всички
абонирани продукти и комплекти
предварително, а в 3 последователни каталога. Ако продукт от вашия
абонамент участва в специална
оферта, ще се възползвате и от нея.
Комплект "Намаляване на
Открийте
ШИРОК
• Натурален астаксантин
• Екстракт от черна боровинка
• Витамин С
• Витамин Е
•
Астаксантин
Приемайте 1-2 капсули
на ден с вода и храна
ПОДЧЕРТАНИ
КЪДРИЦИ
Радвайте се на
подчертани и
подхранени къдрици с продуктите Duologi.
Създадени, за да
подобрят блясъка
и да подхранят скалпа, така че да можете
на къдриците си с увереност.
да се наслаждавате
Помага за поддържане
на косата подхранена, докато нежно я почиства
Rebuilds inner broken bonds
Сияен
см.
ABS, PP, TPR. 46361 15.00 лв. 8.99 лв.
4.60 €
7.99 лв. 6.65 €
и са създадени
4.35 € 1.94 € Най-ниската
47426
Омекотяващ крем за стъпала Feet Up Everyday 150 мл 46375 18.00 лв. 10.99 лв. 9.20 € 5.62 €
Най-ниската цена за периода от 30 дни преди тази оферта е била 7.99 лв. 4.09 €
Освежаващ спрей за стъпала Feet Up Everyday 250 мл 46376 24.00 лв. 15.99 лв.
Най-ниската
12.27 € 8.18 €
Glow Essentials
с
E & B3
125 мл 43908 10.00 лв. 5.49 лв. 5.11 € 2.81 €
за
14 x 4.6 x 2.4 см. Дръжка: TPR, 50% рециклиран PS. Глава: PS и неръждаема стомана.
4.60 € Комплект от 2 сменяеми
4.6 x 3.5 x 2.5 см. Материали: PS, неръждаема стомана. 46413 14.00 лв. 7.99 лв. 7.16 € 4.09 €
6.14 €
Гел-чорапи Feet Up Expert
(22,5 см) Eur 36-39, US 6-8, UK 4-6. Материали:
Гъба за баня Pumpkin
Размер: 8,5х 8,5х 6,5 см.
1 брой. Материал: PE
100%
материали. 48547 12.00 лв.
ЦЕНА 5.99 лв. (–50%)
6.14 € 3.06 € НОВА